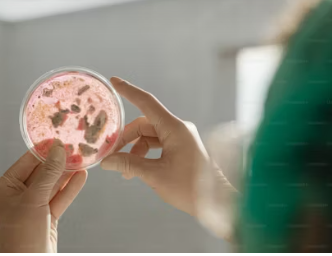
미생물

소개
미생물은 종종 육안으로 보이지 않는 우리 세계의 생물학적 지형을 형성하는 데 중추적인 역할을 합니다. 미생물은 복잡한 생물 생태계 내에서 다각적으로 상호 작용하며 개인의 건강부터 지구 환경 패턴에 이르기까지 모든 것에 영향을 미칩니다. 이 블로그 게시물에서는 생물체 내 미생물 상호 작용의 흥미로운 영역을 탐구하여 자연과 인간의 건강 모두에 대한 미생물의 중요성, 메커니즘 및 의미를 탐구합니다.
상호주의적 미생물 파트너십
복잡한 인생의 춤 속에서 일부 미생물들은 숙주와 공생 관계를 형성하여 양쪽 모두에게 놀라운 혜택을 줍니다. 미생물과 숙주가 상호 이익을 위해 협력하는 상호주의적 미생물 관계는 다양한 생물학적 체계에 걸쳐 있습니다.
인간과 동물의 소화관 내에 거주하는 장내 미생물은 상호주의적 관계의 최전선에 있습니다. 박테리아, 바이러스, 곰팡이 및 기타 미생물로 구성된 이러한 미생물 군집은 소화, 대사 및 면역 체계 조절과 같은 필수 생리적 기능에 기여합니다. 그 대가로 숙주는 미생물이 번성할 수 있는 영양 환경을 제공합니다.
내장을 넘어, 상호주의적인 상호작용은 식물 뿌리가 질소 고정 박테리아와 공생 관계를 형성하는 것을 포함하여 다양한 생태계로 확장되며, 박테리아는 탄수화물의 대가로 식물에 필수적인 영양소를 공급합니다. 유사하게, 산호초는 광합성을 통한 에너지 생산을 위해 공생 조류에 의존하는 반면, 해조류는 산호가 제공하는 영양소와 쉼터로부터 이익을 얻습니다.
상호주의적 미생물 파트너십의 복잡한 역학을 이해하는 것은 생태계 복원력, 농업 생산성 및 인간 건강에 대한 통찰력을 제공합니다. 이러한 상호 작용을 활용하는 것은 프로바이오틱스, 농업 생명 공학 및 생태계 복원과 같은 분야에서 혁신적인 솔루션의 잠재력을 가지고 있습니다.
많은 미생물들이 숙주와 조화롭게 공존하지만, 다른 미생물들은 해로운 영향을 끼쳐 감염병을 일으키고 생물학적 기능을 손상시킵니다. 세균과 바이러스에서부터 곰팡이와 원생동물에 이르기까지 병원성 미생물은 인간과 동물, 식물의 건강에 심각한 위협이 됩니다.
병원체는 숙주 생물에 침입하여 면역 방어를 피하고 숙주 환경 내에서 번식하는 다양한 방법을 사용합니다. 세균성 병원체는 독소를 만들어 숙주 세포에 손상을 입히고, 바이러스는 세포 기계를 탈취하여 복제와 확산을 일으키고, 곰팡이는 효소를 분비하여 숙주 조직을 분해하고, 원생동물은 숙주 세포의 기능을 조작하여 감염을 일으킵니다.
병원성 미생물 상호 작용의 결과는 치명적일 수 있으며 급성 질병, 만성 질환 및 심각한 경우 사망에 이를 수 있습니다. 말라리아, 결핵, 인플루엔자, COVID-19와 같은 질병은 병원성 미생물이 공중 보건 및 사회 경제적 안정에 미치는 전 세계적인 영향을 강조합니다.
병원성 미생물을 퇴치하기 위한 노력은 백신 접종, 항균 요법, 벡터 제어 및 공중 보건 개입을 포함한 다양한 접근 방식을 포함합니다. 또한 게놈 및 계산 기술의 발전은 병원체를 신속하게 식별할 수 있게 하여 질병 발생을 완화하는 표적 치료 및 감시 전략을 용이하게 합니다.
미생물 생태 역학
미생물의 상호작용은 개별 숙주를 넘어 생태계 내의 복잡한 생태 네트워크를 형성합니다. 미생물은 자연 환경에서 서로, 주변의 생물학적 및 비생물적 요인과 복잡한 상호작용을 하며 영양 순환, 에너지 흐름 및 생태계 안정성에 영향을 미칩니다.
미생물 군집은 환경 변화, 자원 가용성, 종간 상호 작용에 대응하는 역동적인 구조와 기능을 나타냅니다. 미생물 생태계에서 관찰되는 다양한 상호 작용 유형에는 경쟁, 포식, 기생 및 상호주의가 있으며, 각각 미생물 군집의 회복력과 적응력에 기여합니다.
미생물 생태 역학을 이해하는 것은 생태계 관리, 생물 다양성 보존 및 환경 정화 노력에 필수적입니다. 미생물 생명 공학은 이러한 생태학적 통찰력을 활용하여 폐수 처리, 토양 비옥도 향상, 오염 완화 및 오염된 장소의 생물 정화를 위한 지속 가능한 솔루션을 개발합니다.
결론
결론적으로 미생물과 그 숙주 또는 환경 사이의 상호 작용은 복잡하고 다면적이며 매우 영향력이 큽니다. 생명을 유지하는 상호주의적 파트너십부터 이를 위협하는 병원성의 만남까지 미생물의 상호 작용은 생물학적 세계를 심오한 방식으로 형성합니다. 이러한 상호 작용의 복잡성을 해결함으로써 우리는 생태계 기능, 인간 건강 및 환경 지속 가능성에 대한 귀중한 통찰력을 얻고 지구가 직면한 당면 과제에 대한 혁신적인 해결의 길을 열어줍니다.